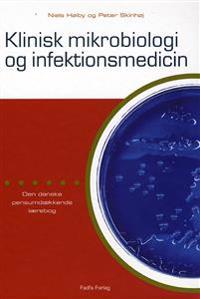
Klinisk Mikrobiologi og Infektionsmedicin

Inbunden
Klinisk Mikrobiologi og Infektionsmedicin
Beskrivning:
Klinisk Mikrobiologi og infektionsmedicin er en udvidet udgave af den tidligere mikrobiologiske lærebog Basal og Klinisk Mikrobiologi. Den er tilpasset den nye studieordning, hvor medicinsk mikrobiologi og infektionsmedicin er stærkt integreret. Den rivende udvikling i fagområderne afspejle [...]
Visa längre beskrivning
Fakta
- Förlag:
- FADL
- ISBN:
- 9788777494239
- Bandtyp:
- Inbunden
- Utgiven:
- 2008
- Språk:
- Danska
- Upplaga:
- 1
- Antal Sidor:
- 564
- ISBN-10:
- 8777494237
Priser hos nätbutiker
| Butik | Mervärde | Pris | Tillgänglighet | Leveranstid | Inkl frakt | Länkar |
|---|---|---|---|---|---|---|
 |
Nordens största bokhandel med över 10 miljoner titlar. Alltid låga priser | 912.00 kr | I lager | 2-5 dagar | 912.00 kr | Till butik |
Obs! Glöm inte att alltid kolla priset hos återförsäljaren!

